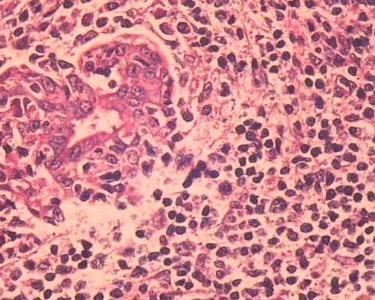

原发性腮腺淋巴瘤
概述
病因
原发性腮腺淋巴瘤的发生与放射线有密切关系。早在20世纪60年代就有把涎腺肿瘤作为放疗后并发症的报道。另外,病毒感染以及经常暴露在烟雾、灰尘中和接触化学品可能也与该病的发生有关。
低度恶性的边缘区B细胞性淋巴瘤和黏膜相关性淋巴瘤常常发生于良性的淋巴上皮性病变和肌上皮涎腺炎,而肌上皮涎腺炎通常与自身免疫病有关,无自身免疫病的病人则很少发生该病。因此,推测该病与腮腺炎症及免疫功能紊乱有关。
临床表现
 常见症状有进行性增大的非固定性肿块,一般为单侧无痛性的。有时可出现局部疼痛,颈部淋巴结肿大或面神经麻痹。一些罕见的病例可同时出现下颌下腺的侵犯。也可出现病变侵犯皮肤或深部组织。并可同时共存一些自身免疫病,如类风湿性关节炎等。
常见症状有进行性增大的非固定性肿块,一般为单侧无痛性的。有时可出现局部疼痛,颈部淋巴结肿大或面神经麻痹。一些罕见的病例可同时出现下颌下腺的侵犯。也可出现病变侵犯皮肤或深部组织。并可同时共存一些自身免疫病,如类风湿性关节炎等。
诊断
根据腮腺部位出现的无痛性肿块,经手术活检、病理组织学检查确诊。80%的病人在诊断时为Ⅰ、Ⅱ期。原发性腮腺淋巴瘤采用AnnArbor分期。但该病的误诊率较高,原因是就诊时常常怀疑其他恶性肿瘤,而很少想到该病。
鉴别诊断
原发性腮腺淋巴瘤需与肌上皮涎腺炎、恶性混合瘤、腺泡细胞癌、黏液表皮样癌、腺样囊腺癌、未分化癌等区别。特别是黏膜相关性淋巴瘤与肌上皮涎腺炎的区别较困难,后者常被误诊为“假性淋巴瘤”,免疫组化和流式细胞仪对区别二者是有帮助的,大多数恶性淋巴瘤可显示异常的免疫表型和免疫球蛋白轻链限制,分子遗传学分析可显示免疫球蛋白基因重排为单克隆性。
治疗
附件列表
词条内容仅供参考,如果您需要解决具体问题
(尤其在法律、医学等领域),建议您咨询相关领域专业人士。